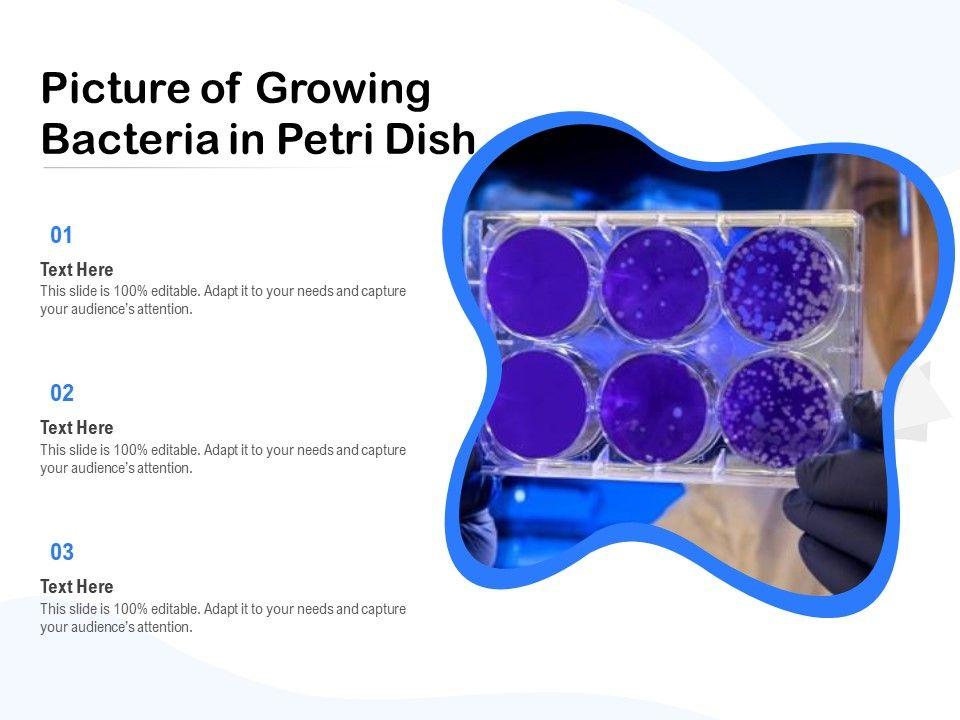
default_img

AI PPT Maker
Templates
PPT Bundles
Design Services
Business PPTs
Business Plan
Management
Strategy
Introduction PPT
Roadmap
Self Introduction
Timelines
Process
Marketing
Agenda
Technology
Medical
Startup Business Plan
Cyber Security
Dashboards
SWOT
Proposals
Education
Pitch Deck
Digital Marketing
KPIs
Project Management
Product Management
Artificial Intelligence
Target Market
Communication
Supply Chain
Google Slides
Research Services
One PagersAll Categories
Picture Of Growing Bacteria In Petri Dish Ppt PowerPoint Presentation Gallery Graphic Tips PDF
Features of these PowerPoint presentation slides:
Showcasing this set of slides titled picture of growing bacteria in petri dish ppt powerpoint presentation gallery graphic tips pdf. The topics addressed in these templates are picture of growing bacteria in petri dish. All the content presented in this PPT design is completely editable. Download it and make ajustments in color, background, font etc. as per your unique business setting.
People who downloaded this PowerPoint presentation also viewed the following :
Related Products
Picture Of Growing Bacteria In Petri Dish Ppt PowerPoint Presentation Gallery Graphic Tips PDF with all 2 slides:
Ratings and Reviews
4
- ★50
- ★41
- ★30
- ★20
- ★10
Write a review
Most Relevant Reviews
by tumpa singha ray
January 27, 2021
Really like the color and design of the presentation.
View per page:
10